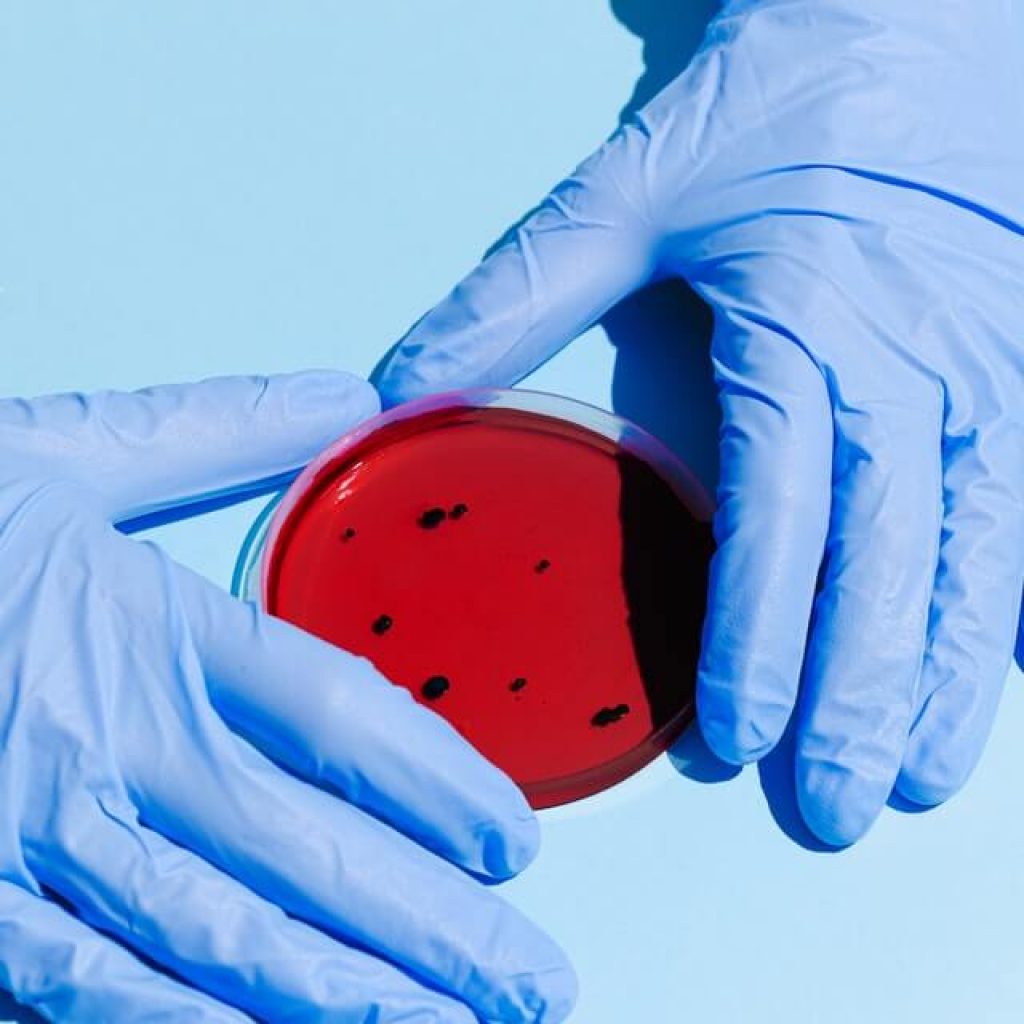

About Us
Our Motto: “Maximize your network”
ABAAL Group is a service oriented company established by young entrepreneur with a vision to create a first class integrated services structure and other business solutions within the entire East African, Middle and far east countries.
ABAAL Group has a dedicated team of experts working around the clock to make sure that our customers get the best contacts, information, business management and, which they need to become more profitable, better informed and competitive for all their business.
Complete Transections
Expert Staff

OUR CORE VALUES
Integrity
The morality of all commitments to our customers, employees, and shareholders.
Quality
Put the interests of our customers first and be dedicated to providing an individualized business experience.
Growth and Profitability
dedicated to continuous innovation and search for new ideas and opportunities to accelerate profitable growth.
Address
ABAAL GROUP, Floor 5, DAFZA 8W, Dubai, United Arabic Emirates
Call Us
+971 50 403 6312
Email Us
info@abaalgroup.com




